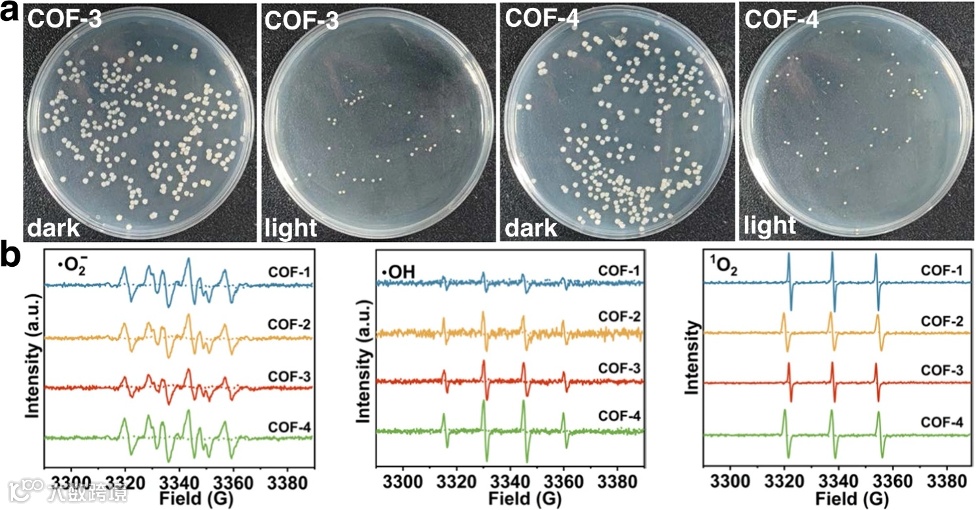

第一作者:Zhongshan Chen
通讯作者:王祥科教授、杨慧副教授、马胜前教授
通讯单位:华北电力大学、北德克萨斯大学
DOI: 10.1038/s41467-023-36710-x
共价有机框架(COFs)是一类新兴的有机光催化剂。然而,其复杂的结构通常导致光催化活性位点和反应机理的不确定性。在本文中,作者采用框架化学策略成功地构建出一系列网状晶体酰肼基COF光催化剂,其光电特性与局部孔特征可通过不同的连接配体进行调控。同时,利用大量的实验测试和理论计算深入探究了分子水平上COFs中的激发态电子分布和传输路径。在所设计出的COFs中,COF-4表现出优异的激发态电子利用效率和电荷传输特性,实现中性海水介质中高达6.84 mg/g/day的光催化铀提取性能,为迄今为止所有技术中的最高纪录。该研究提供了COF基光催化剂性能调控的深入理解,并为面向多种应用的先进COF光催化剂设计提供了有效指导。
共价有机框架(COFs)因其具有组分、结构和孔隙率的可调控性优势,近年来在吸附、传感、催化、能量储存/转化和环境修复等领域中得到广泛的应用。得益于大量的连接配体可作为光吸收组分、电子给体、电子受体等,COFs在光催化领域中也表现出卓越的前景。然而,快速电荷(电子-空穴)复合、瞬态组分的不稳定性以及电荷激发和迁移过程中的能量损失等问题会大大降低COFs的光催化活性,且光生电荷的有效分离通常需要采用牺牲剂,这些缺点阻碍着COF基光催化剂的实际应用。
设计具有高活性和低成本的COF光催化剂是目前相关领域的研究热点,其涉及包括化学、材料科学、催化和工程在内的多个领域。为获得高性能的COF光催化剂,科研人员致力于开发可拓宽可见光吸收范围、优化能带结构、以及减少光生电子和空穴复合等有效策略。实现上述性能提升的常见策略包括:(i)在框架中引入光敏剂以提高光收集能力;(ii)对连接配体进行功能化修饰并调控组分以优化带隙能和价带/导带电位;(iii)构建给体-受体组分以提高电荷传输动力学和电荷载流子分离效率;(iv)掺杂非金属元素(N, P, S等)、金属单原子位点、簇或贵金属作为助催化剂以调控光电特性,从而提高整体光催化活性。上述策略表明,调控COFs中的电子能级和电子传输,对于提高其光催化性能至关重要。
近年来,海水提铀受到广泛关注,因为核能有助于降低人对化石燃料的依赖,并减少人为CO2排放。开发从海水中提取铀的可持续策略,可确保为将来提供可靠的铀燃料,同时对处理核工业废水和受污染的地下水至关重要。其中,COF基吸附型光催化剂系统已应用于海水提铀领域。目前,所开发出的系统具有相对较低的U(VI)还原活性和/或需要牺牲剂以促进光生电荷分离。此外,COFs复杂的结构通常导致催化位点的不确定性,这阻碍着科研人员对其反应机理的深入理解。该领域的另一个挑战是有限的太阳光吸收和电荷载流子利用效率,这两者均取决于分子水平上的COF结构和电子传输路径。减少电子从激发态传输至受体(如吸附的UO22+)过程中的能量损失,并同时减少荧光发射,对于提高光催化性能至关重要。

图1. (a) COF光催化剂的电荷载流子分离与利用示意图,强调了电荷传输过程中所涉及的能级。(b)从COF给体至U(VI)受体的电荷传输示意图(强调了不同的利用效率),该特性可通过调控激发态电子分布来优化。(c)具有不同组分的COF-1至COF-4结构,通过调控激发态电子结构和电荷传输特性,从而促进海水提铀光催化活性。

图2. (a) COF-1, COF-2, COF-3和COF-4的固态13C CP/MAS NMR谱。(b-e) COF-1, COF-2, COF-3和COF-4的PXRD衍射实验测试和拟合结果,以及相应的Pawley精修。插图为假设AA堆叠模式下每个COF的结构模型和层间距。(f) COF-1, COF-2, COF-3和COF-4的SEM图。

图3. (a) COF-1, COF-2, COF-3和COF-4在77K温度下的N2吸脱附曲线。(b)所计算出COF-1, COF-2, COF-3和COF-4的孔径分布。(c) COF-1, COF-2, COF-3和COF-4在1M HNO3中处理24 h后的PXRD衍射。(d) COF-1, COF-2, COF-3和COF-4的电化学阻抗谱(EIS)。(e) COF-1, COF-2, COF-3和COF-4的Kubelka-Munk曲线。(f) COF-1, COF-2, COF-3和COF-4的Mott-Schottky曲线。(g) COF-1, COF-2, COF-3和COF-4的瞬态电流密度。(h) COF-1, COF-2, COF-3和COF-4的能带位置。(i) COF-1, COF-2, COF-3和COF-4在黑暗和可见光照射下的EPR导带电子谱。

图4. (a)在初始铀浓度约为20 ppm的海水中,COF-1, COF-2, COF-3和COF-4光催化剂的提铀性能。(b)在初始铀浓度约为10 ppm的地下水中,COF-1, COF-2, COF-3和COF-4光催化剂的提铀性能。(c)在提铀完成后,COF-3和COF-4的U LIII-edge XANES谱,其中UO2(NO3)2·6H2O, UO2和UO3作为对照。(d) COF-3和COF-4在光催化过程后的EXAFS拟合曲线。(e) COF-3和COF-4的小波变换,其中UO2(NO3)2·6H2O和UO2作为对照。(f) COF-3和COF-4在光催化过程后的U 4f XPS谱。(g)在含铀海水中完成光催化过程后,COF-4的HRTEM图。(h) COF-4与此前报道的其它材料在天然海水中提铀性能的比较。

图5. (a) COF光催化剂的PL寿命。(b) COF-3和(c) COF-4的瞬态吸收光谱。(d) COF光催化剂的飞秒时间分辨率瞬态吸收衰减动力学。(e) COF光催化剂上的铀吸附和还原相对自由能。(f)四组[U(VI)O2(H2O)2]@COF单线态的S1激发态振子强度和摩尔吸收系数。(g) COF光催化剂的S1激发态电子结构。(h)光催化前后COFs的Hirshfeld电荷。
图6. (a)在黑暗中和可见光照射下,采用COF-3和COF-4处理后的海洋细菌菌落照片。(b) COF-1, COF-2, COF-3和COF-4在可见光照射下形成•O2-DMPO, •OH-DMPO和1O2-TEMP络合物的EPR谱。
总而言之,本文设计出一种新型框架化学策略,成功构建出一系列具有独特光电特性和优异光催化活性的高度共轭酰肼基COF光催化剂。通过优化COFs中的激发态电子分布、给电子位点和电子传输特性,可以最大限度地提升从海水和废水中的光催化U(VI)提取性能。在所设计出的COFs中,COF-4光催化剂在天然海水中表现出高达6.84mg/g/day的提铀性能,性能优于此前报道的其它COF基吸附剂和吸附型光催化剂。该研究提供了COFs光催化剂在运行过程中有关电荷分离和传输机制的深入理解,并为面向海水提铀和其它光催化应用的先进COFs设计提供了有效指导。
【文献来源】
Zhongshan Chen, Jingyi Wang, Mengjie Hao, Yinghui Xie, Xiaolu Liu, Hui Yang, Geoffrey I. N. Waterhouse, Xiangke Wang, Shengqian Ma. Tuning excited state electronic structure and charge transport in covalent organic frameworks for enhanced photocatalytic performance. Nat. Commun. 2023. DOI: 10.1038/s41467-023-36710-x.
文献链接:https://doi.org/10.1038/s41467-023-36710-x
声明
“邃瞳科学云”直播服务
扫描二维码下载
邃瞳科学云APP

